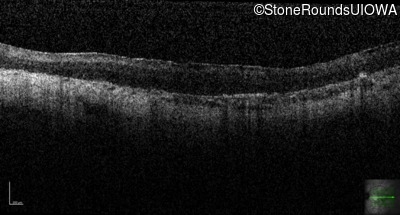
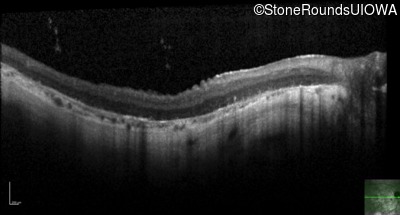
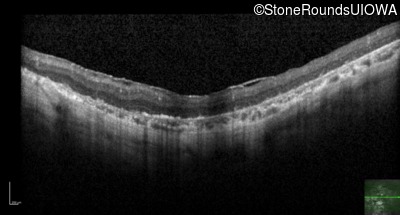
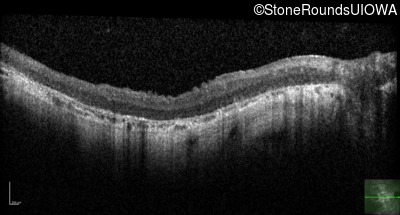
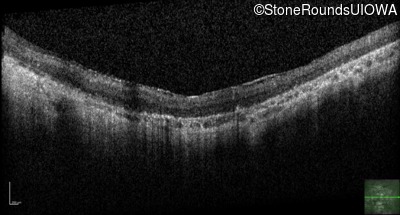
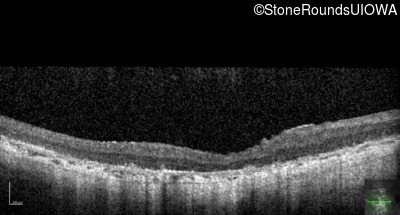
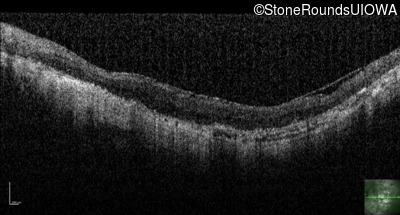
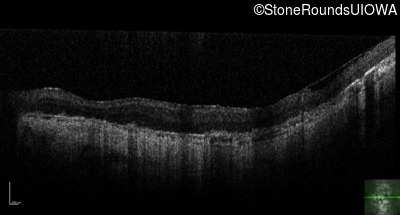
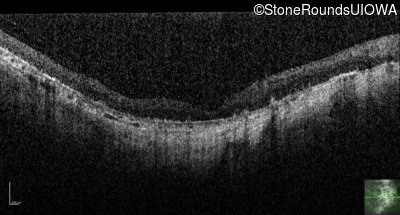
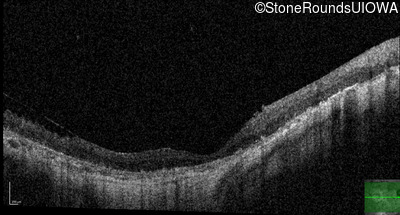
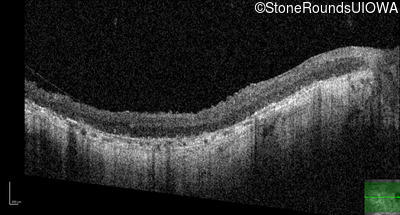
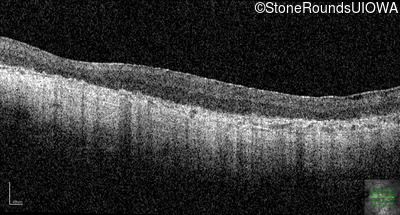
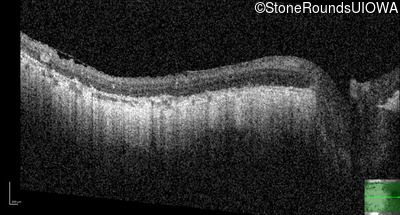
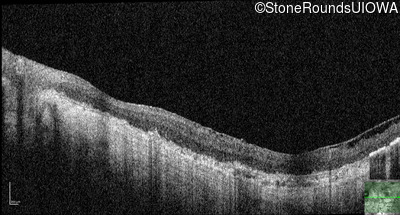

Case
SR56
Student Mode
Bardet Biedl Syndrome (IB2)
Male
Male
Hidden
SR56
Student Mode
Bardet Biedl Syndrome (IB2)
Male
Male
Highlighted Images
| Age at visit: 33 years | OD | OS |
|---|---|
History
This 33 year old man first had difficulty with his vision at age 11 when he bumped into things in dim light. He had an extra digit on the postaxial side of both feet.
| Age at visit: 22 years |
| Age at visit: 31 years |
| Age at visit: 32 years |
| Age at visit: 33 years |
| Age at visit: 34 years |
| Age at visit: 36 years |
| Age at visit: 37 years |
| Age at visit: 38 years |
| Age at visit: 39 years |
| Age at visit: 41 years |
| Age at visit: 42 years |
| Age at visit: 43 years |
| Age at visit: 45 years |
| OD | OS | ||
|---|---|---|---|
Diagnosis & molecular findings
| Disease | Gene | Allele 1 variant(s) | Allele 2 variant(s) | Inheritance mode |
|---|---|---|---|---|
| Bardet Biedl Syndrome | BBS1 | Met390Arg ATG>AGG | Met390Arg ATG>AGG | AR |
Disease:
Gene:
Allele 1:
Met390Arg ATG>AGG
Allele 2:
Met390Arg ATG>AGG
Inheritance:
AR